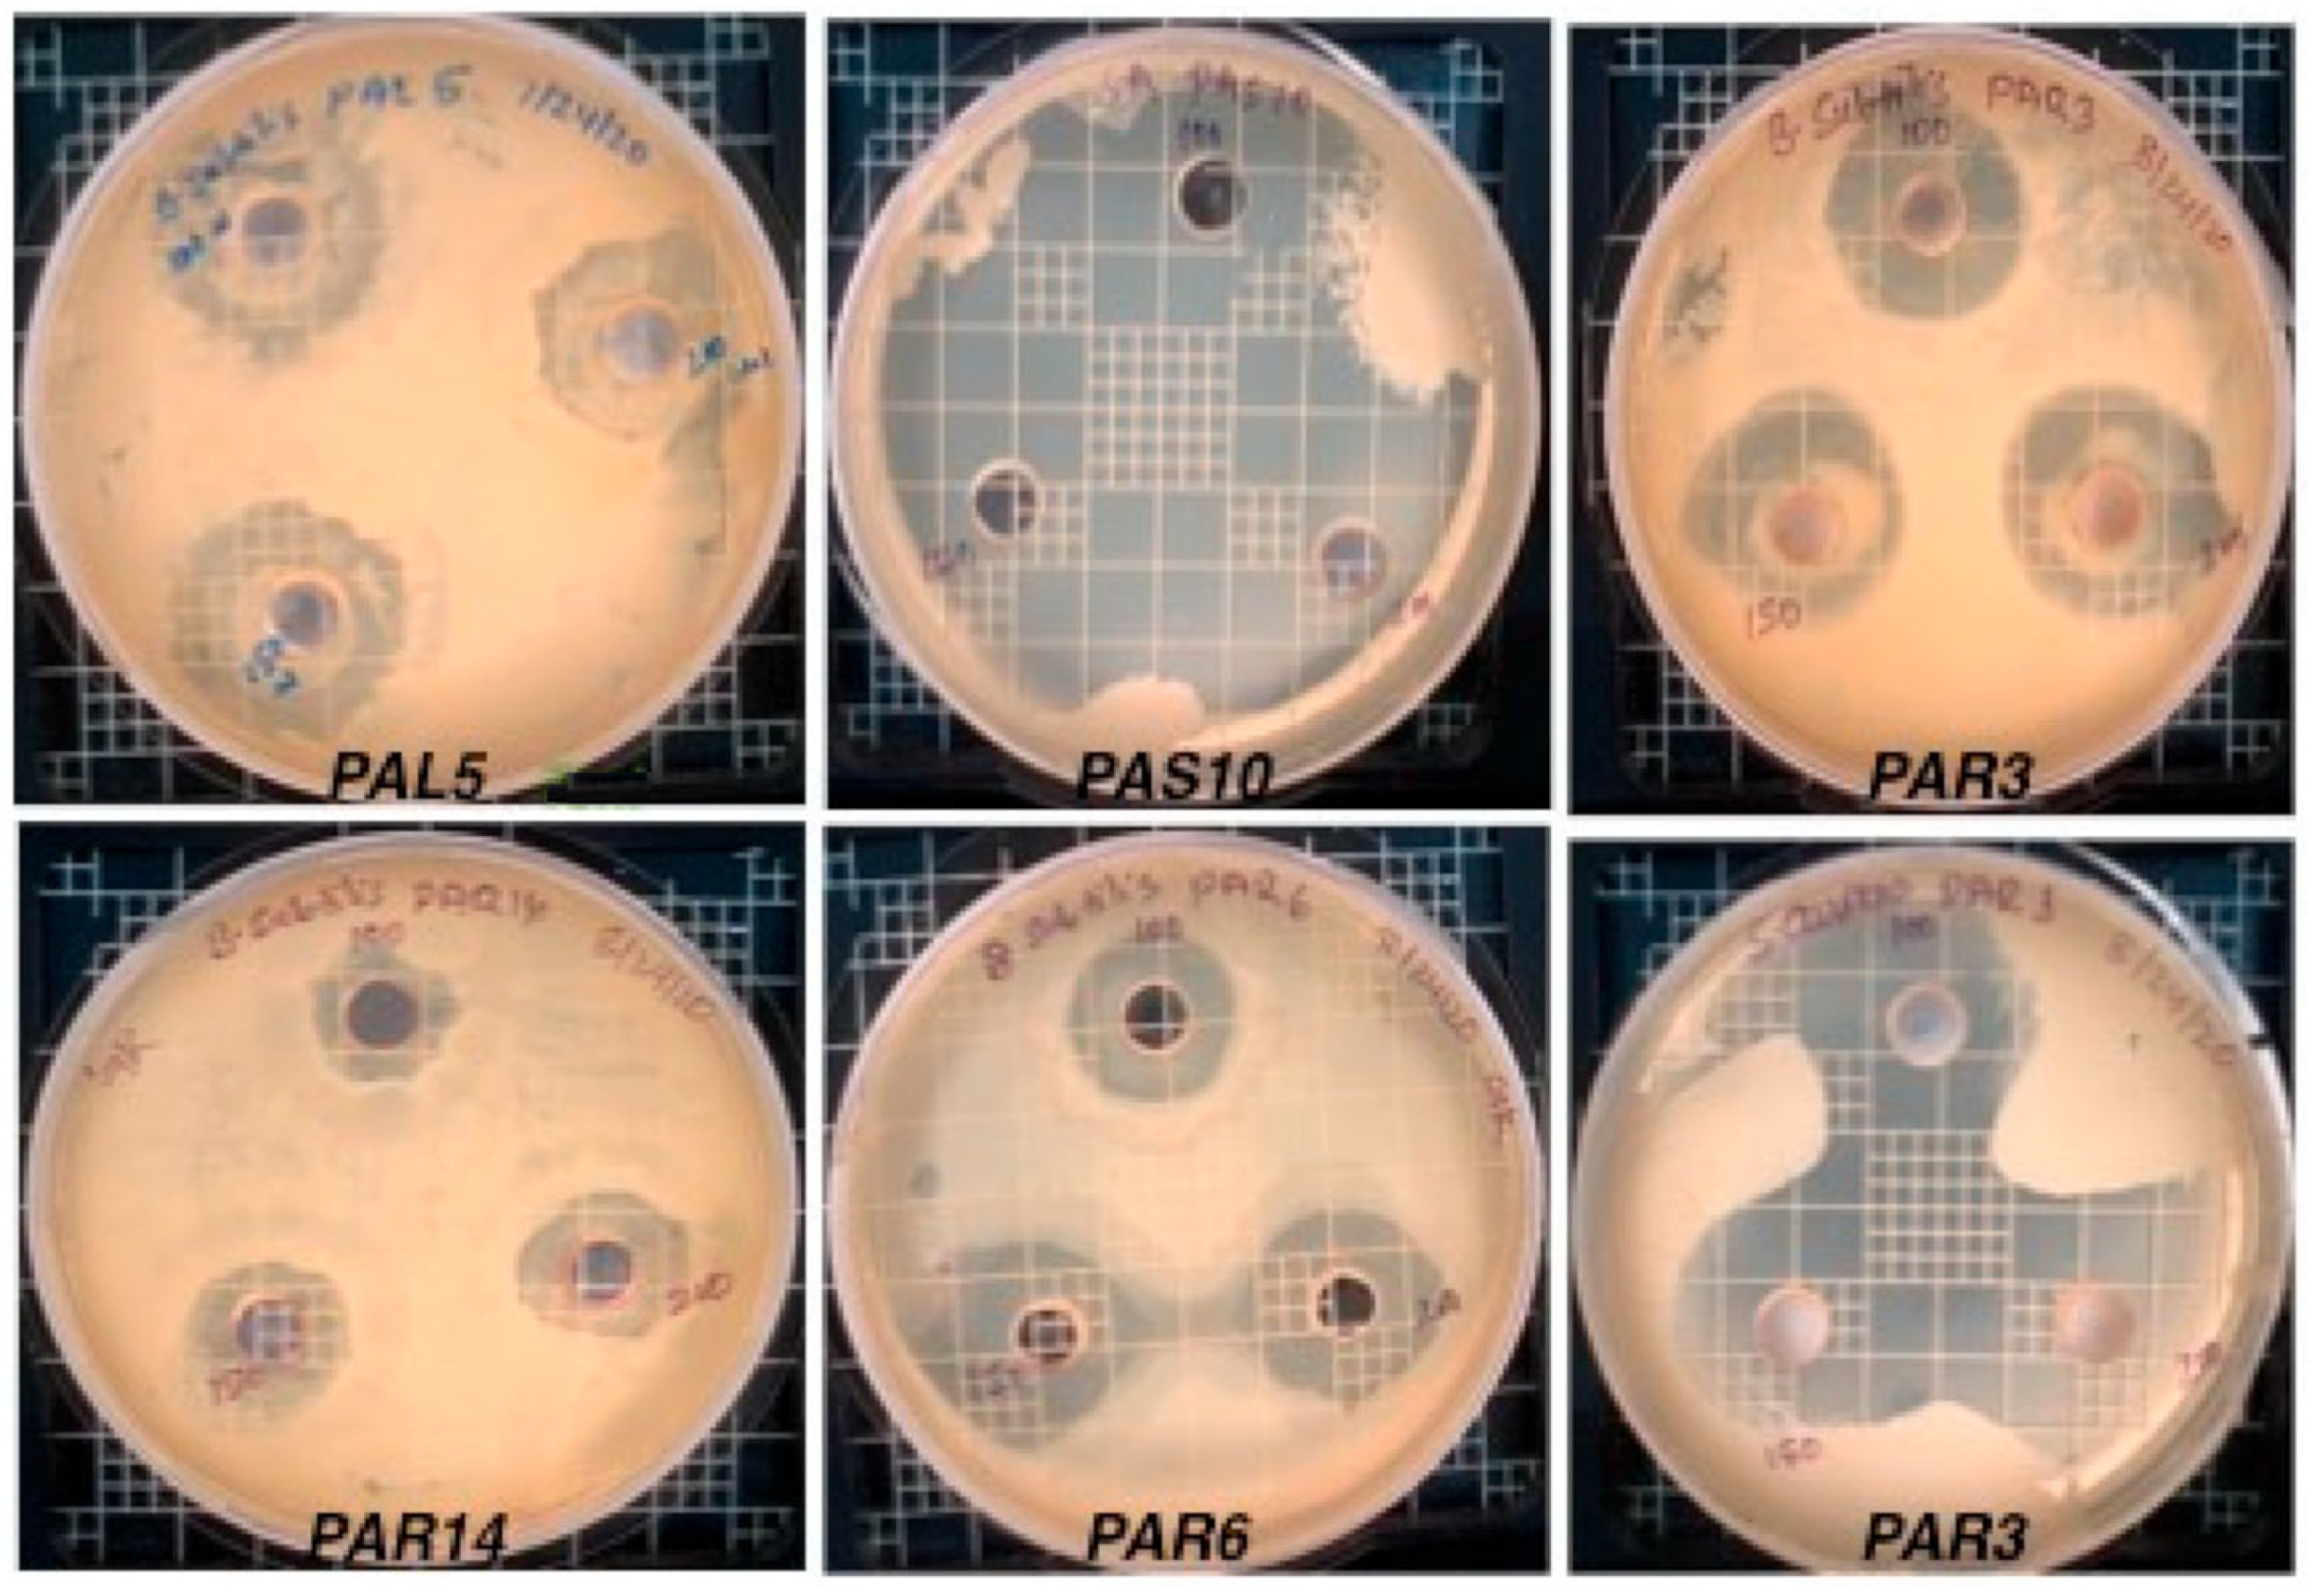
Microbiolres 14 00100 g002

Isolation and Characterization of Fungal Endophytes from Petiveria alliacea and Their Antimicrobial Activities in South Florida
Abstract
:1. Introduction
2. Materials and Methods
2.1. Collection of Host Medicinal Plants
2.2. Isolation of Endophytic Fungi
2.3. Crude Extract Preparation for Secondary Metabolites
2.4. Testing of Antibacterial and Antifungal Activity
2.5. Sequencing of Endophytic Isolates
2.6. Statistical Analysis
3. Results
3.1. Collection and Pure Culture Isolation
3.2. Antimicrobial Activity of Crude Fungal Extract Using Agar Well Diffusion Method
3.3. Molecular Characterization
3.4. Statistical Analysis
4. Discussion
5. Conclusions
Author Contributions
Funding
Institutional Review Board Statement
Informed Consent Statement
Data Availability Statement
Acknowledgments
Conflicts of Interest
References
- Sen, S.; Chakraborty, R. Revival, Modernization and Integration of Indian Traditional Herbal Medicine in Clinical Practice: Importance, Challenges and Future. J. Tradit. Complement. Med. 2017, 7, 234–244. [Google Scholar] [CrossRef] [PubMed]
- Hussain, S.; Hussain, W.; Nawaz, A.; Badshah, L.; Ali, A.; Ullah, S.; Ali, M.; Hussain, H.; Bussmann, R.W. Quantitative Ethnomedicinal Study of Indigenous Knowledge on Medicinal Plants Used by the Tribal Communities of Central Kurram, Khyber Pakhtunkhwa, Pakistan. Ethnobot. Res. Appl. 2022, 23, 1–31. [Google Scholar] [CrossRef]
- Bussmann, R.W. The Globalization of Traditional Medicine in Northern Perú: From Shamanism to Molecules. Evid.-Based Complement. Altern. Med. 2013, 2013, 291903. [Google Scholar] [CrossRef] [PubMed]
- Patwardhan, B.; Vaidya, A.; Science, M.C. Ayurveda and Natural Products Drug Discovery. Curr. Sci. 2004, 86, 789–799. [Google Scholar]
- Singh, D.B.; Pathak, R.K.; Rai, D. From Traditional Herbal Medicine to Rational Drug Discovery: Strategies, Challenges, and Future Perspectives. Rev. Bras. Farmacogn. 2022, 32, 147–159. [Google Scholar] [CrossRef]
- Carroll, G. Fungal Endophytes in Stems and Leaves: From Latent Pathogen to Mutualistic Symbiont. Ecology 1988, 69, 2–9. [Google Scholar] [CrossRef]
- Faeth, S.H.; Hammon, K.E. Fungal Endophytes in Oak Trees: Long-Term Patterns of Abundance and Associations with Leafminers. Ecology 1997, 78, 810–819. [Google Scholar] [CrossRef]
- Saikkonen, K.; Faeth, S.H.; Helander, M.; Sullivan, T.J. Fungal Endophytes: A Continuum of Interactions with Host Plants. Annu. Rev. Ecol. Syst. 1998, 29, 319–343. [Google Scholar] [CrossRef]
- Newman, D.J.; Cragg, G.M. Plant Endophytes and Epiphytes: Burgeoning Sources of Known and “Unknown” Cytotoxic and Antibiotic Agents? Planta Med. 2020, 86, 891–905. [Google Scholar] [CrossRef]
- Pasrija, P.; Girdhar, M.; Kumar, M.; Arora, S.; Katyal, A. Endophytes: An Unexplored Treasure to Combat Multidrug Resistance. Phytomed. Plus 2022, 2, 100249. [Google Scholar] [CrossRef]
- Gouda, S.; Das, G.; Sen, S.K.; Shin, H.S.; Patra, J.K. Endophytes: A Treasure House of Bioactive Compounds of Medicinal Importance. Front. Microbiol. 2016, 7, 1538. [Google Scholar] [CrossRef] [PubMed]
- Ganley, J.C.; Thomas, F.S.; Seebauer, E.G.; Masel, R.I. A Priori Catalytic Activity Correlations: The Difficult Case of Hydrogen Production from Ammonia. Catal. Lett. 2004, 96, 117–122. [Google Scholar] [CrossRef]
- Alvin, A.; Miller, K.I.; Neilan, B.A. Exploring the Potential of Endophytes from Medicinal Plants as Sources of Antimycobacterial Compounds. Microbiol. Res. 2014, 169, 483–495. [Google Scholar] [CrossRef]
- Beare, N. Pirates, Pineapples, and People: A History, Tales, and Legends of the Upper Florida Keys; Papamoa Press: London, UK, 2019. [Google Scholar]
- Sarma, S.N.; Siwach, D.; Hasan, A.; Mittal, P.; Paul, P. Systematic Review on Safety and Efficacy of Saw Palmetto as a Health Supplement for Prostate Health in Adult Males. J. Curr. Med. Res. Opin. 2022, 5, 1252–1270. [Google Scholar]
- Cronquist, A. The Evolution and Classification of Flowering Plants. New York Botanical Garden, Bronx. 1988. Available online: https://www.scirp.org/(S(lz5mqp453edsnp55rrgjct55))/reference/ReferencesPapers.aspx?ReferenceID=1564967 (accessed on 18 August 2023).
- Duarte, M.; Fitoterapia, J.L. Leaf and Stem Morphoanatomy of Petiveria alliacea. Fitoterapia 2005, 76, 599–607. [Google Scholar] [CrossRef]
- Joly, A. Botânica: Introdução à Taxonomia Vegetal; Companhia Editora Nacional: São Paulo, Brasil, 1979; Available online: https://books.google.co.jp/books/about/Botanica.html?id=SBnKwgEACAAJ&redir_esc=y (accessed on 3 January 2023).
- Arogbodo, J.; Igbe, F.; Osho, I.; Adebayo, I. Processing Yield Percentage and Phytochemical Appraisement of the Leaf, Stem-Bark, Inflore-Infructescence, and Root of Petiveria alliacea (Linneaus). Int. J. Sci. Res. Biol. Sci. 2021, 8, 65–70. [Google Scholar]
- Williams, L.A.D.; The, T.L.; Gardner, M.T.; Fletcher, C.K.; Naravane, A.; Gibbs, N.; Fleishacker, R. Immunomodulatory Activities of Petiveria alliacea L. Phytother. Res. Int. J. Devoted Med. Sci. Res. Plants Plant Prod. 1997, 11, 251–253. [Google Scholar]
- Marini, S.; Jovicevic, L.; Milanese, C. Effects of Petiveria alliacea L. on Cytokine Production and Natural Killer Cell Activity. Pharmacol. Res. 1993, 27, 107–109. [Google Scholar] [CrossRef]
- Tan, X.; Zhou, Y.; Zhou, X.; Xia, X.; Wei, Y.; He, L.; Tang, H.; Yu, L. Diversity and Bioactive Potential of Culturable Fungal Endophytes of Dysosma Versipellis; A Rare Medicinal Plant Endemic to China. Sci. Rep. 2018, 8, 5929. [Google Scholar] [CrossRef]
- Sharma, D.; Pramanik, A.; Agrawal, P.K. Evaluation of Bioactive Secondary Metabolites from Endophytic Fungus Pestalotiopsis neglecta BAB-5510 Isolated from Leaves of Cupressus torulosa D.Don. 3 Biotech 2016, 6, 210. [Google Scholar] [CrossRef]
- Pansanit, A.; Pripdeevech, P. Antibacterial Secondary Metabolites from an Endophytic Fungus, Arthrinium Sp. MFLUCC16-1053 Isolated from Zingiber cassumunar. Mycology 2018, 9, 264–272. [Google Scholar] [CrossRef] [PubMed]
- White, T.J.; Bruns, T.; Lee, S.; Taylor, J. Amplification and Direct Sequencing of Fungal Ribosomal RNA Genes for Phylogenetics. PCR Protoc. Guide Methods Appl. 1990, 18, 315–322. [Google Scholar]
- Shabana, A.M.I.; Shetaia, Y.M.; Abdelwahed, N.A.M.; Esawy, M.A.; Alfarouk, O.R. Optimization, Purification and Antitumor Activity of Kodamaea ohmeri ANOMY L-Asparaginase Isolated from Banana Peel. Curr. Pharm. Biotechnol. 2021, 22, 654–671. [Google Scholar] [CrossRef] [PubMed]
- Sun, Y.; Wang, Q.; Lu, X.D.; Okane, I.; Kakishika, M. Endophytic Fungi Associated with Two Suaeda Species Growing in Alkaline Soil in China. Mycosphere 2011, 2, 239–248. [Google Scholar]
- Husna; Budi, S.W.; Mansur, I.; Kusmana, D.C. Diversity of Arbuscular Mycorrhizal Fungi in the Growth Habitat of Kayu Kuku (Pericopsis mooniana Thw.) in Southeast Sulawesi. Pak. J. Biol. Sci. 2015, 18, 1–10. [Google Scholar] [CrossRef]
- Hata, K.; Futai, K. Endophytic Fungi Associated with Healthy Pine Needles and Needles Infested by the Pine Needle Gall Midge, Thecodiplosis japonensis. Can. J. Bot. 1995, 73, 384–390. [Google Scholar] [CrossRef]
- Wang, Q.-X.; Li, S.-F.; Zhao, F.; Dai, H.-Q.; Bao, L.; Ding, R.; Gao, H.; Zhang, L.-X.; Wen, H.-A.; Liu, H.-W. Chemical Constituents from Endophytic Fungus Fusarium oxysporum. Fitoterapia 2011, 82, 777–781. [Google Scholar] [CrossRef]
- Pelaez, F. Biological Activities of Fungal Metabolites. Handb. Ind. Mycol. 2004, 22, 41–92. [Google Scholar]
- Sun, X.; Mycology, L.G. Endophytic Fungal Diversity: Review of Traditional and Molecular Techniques. Mycopathologia 2012, 3, 65–76. [Google Scholar]
- Gamboa, M.A.; Laureano, S.; Bayman, P. Measuring Diversity of Endophytic Fungi in Leaf Fragments: Does Size Matter? Mycopathologia 2003, 156, 41–45. [Google Scholar] [CrossRef]
- Garcia, A.; Rhoden, S.A.; Bernardi-Wenzel, J.; Orlandelli, R.C.; Azevedo, J.L.; Pamphile, J.A. Antimicrobial Activity of Crude Extracts of Endophytic Fungi Isolated from Medicinal Plant Sapindus saponaria L. J. Appl. Pharm. Sci. 2012, 2, 35. [Google Scholar] [CrossRef]
- Idris, A.; Al-tahir, I.; Idris, E. Antibacterial Activity of Endophytic Fungi Extracts from the Medicinal Plant Kigelia africana. Egypt. Acad. J. Biol. Sci. G. Microbiol. 2013, 5, 1–9. [Google Scholar] [CrossRef]
- Musah, R.A.; Kim, S.; Kubec, R. Antibacterial and Antifungal Activity of Sulfur-Containing Compounds from Petiveria alliacea L. Phosphorus Sulfur. Silicon Relat. Elem. 2005, 180, 1455–1456. [Google Scholar] [CrossRef]
- Elghaffar, R.Y.A.; Amin, B.H.; Hashem, A.H.; Sehim, A.E. Promising Endophytic Alternaria alternata from Leaves of Ziziphus spina-Christi: Phytochemical Analyses, Antimicrobial and Antioxidant Activities. Appl. Biochem. Biotechnol. 2022, 194, 3984–4001. [Google Scholar] [CrossRef] [PubMed]
- Vasundhara, M.; Kumar, A.; Reddy, M.S. Molecular Approaches to Screen Bioactive Compounds from Endophytic Fungi. Front. Microbiol. 2016, 7, 1774. [Google Scholar] [CrossRef] [PubMed]
- Tan, X.M.; Wang, C.L.; Chen, X.M.; Zhou, Y.Q.; Wang, Y.Q.; Luo, A.X.; Liu, Z.H.; Guo, S.X. In Vitro Seed Germination and Seedling Growth of an Endangered Epiphytic Orchid, Dendrobium Officinale, Endemic to China Using Mycorrhizal Fungi (Tulasnella sp.). Sci. Hortic. 2014, 165, 62–68. [Google Scholar] [CrossRef]
- Xiong, Z.Q.; Yang, Y.Y.; Zhao, N.; Wang, Y. Diversity of Endophytic Fungi and Screening of Fungal Paclitaxel Producer from Anglojap Yew, Taxus x Media. BMC Microbiol. 2013, 13, 71. [Google Scholar] [CrossRef]
- Jayatilake, P.L.; Munasinghe, H. Antimicrobial Activity of Cultivable Endophytic and Rhizosphere Fungi Associated with “Mile-a-Minute,” Mikania cordata (Asteraceae). Biomed. Res. Int. 2020, 2020, 5292571. [Google Scholar] [CrossRef]
- Shiono, Y.; Shibuya, F.; Murayama, T.; Koseki, T.; Poumale Poumale, H.M.; Tchaleu Ngadjui, B. A Polyketide Metabolite from an Endophytic Fusarium equiseti in a Medicinal Plant. Z. Naturforschung—Sect. C J. Biosci. 2013, 68B, 289–292. [Google Scholar] [CrossRef]
- Brady, S.F.; Clardy, J. CR377, a New Pentaketide Antifungal Agent Isolated from an Endophytic Fungus. J. Nat. Prod. 2000, 63, 1447–1448. [Google Scholar] [CrossRef]
- Lee, J.C.; Lobkovsky, E.; Pliam, N.B.; Strobel, G.; Clardy, J. Subglutinols A and B: Immunosuppressive Compounds from the Endophytic Fungus Fusarium subglutinans. J. Org. Chem. 1995, 60, 7076–7077. [Google Scholar] [CrossRef]
- Sogra Fathima, B.; Balakrishnan, R.M. Biosynthesis and Optimization of Silver Nanoparticles by Endophytic Fungus Fusarium solani. Mater. Lett. 2014, 132, 428–431. [Google Scholar] [CrossRef]
- Farhat, H.; Urooj, F.; Tariq, A.; Sultana, V.; Ansari, M.; Ahmad, V.U.; Ehteshamul-Haque, S. Evaluation of Antimicrobial Potential of Endophytic Fungi Associated with Healthy Plants and Characterization of Compounds Produced by Endophytic Cephalosporium and Fusarium solani. Biocatal. Agric. Biotechnol. 2019, 18, 101043. [Google Scholar] [CrossRef]
- Ginting, R.C.B.; Sukarno, N.; Widyastuti, U.T.U.T.; Darusman, L.K.; Kanaya, S. Diversity of Endophytic Fungi from Red Ginger (Zingiber officinale Rosc.) Plant and Their Inhibitory Effect to Fusarium oxysporum Plant Pathogenic Fungi. Hayati 2013, 20, 127–137. [Google Scholar] [CrossRef]
- Wei, F.; Zhang, Y.; Shi, Y.; Feng, H.; Zhao, L.; Feng, Z.; Zhu, H. Evaluation of the Biocontrol Potential of Endophytic Fungus Fusarium solani CEF559 against Verticillium dahliae in Cotton Plant. Biomed. Res. Int. 2019, 2019, 3187943. [Google Scholar] [CrossRef] [PubMed]
- Tayung, K.; Bp, B.; Dk, J.; Dc, D. Identification and Characterization of Antimicrobial Metabolite from an Endophytic Fungus, Fusarium solani Isolated from Bark of Himalayan Yew. Mycosphere 2011, 2, 203–213. [Google Scholar]
- Latz, M.A.C.; Jensen, B.; Collinge, D.B.; Jørgensen, H.J.L. Endophytic Fungi as Bio-Control Agents: Elucidating Mechanisms in Disease Suppression. Plant Ecol. Divers. 2018, 11, 555–567. [Google Scholar] [CrossRef]
- Wani, S.H.; Kumar, V.; Shriram, V.; Sah, S.K.; Kumar, S. Phytohormones and Their Metabolic Engineering for Abiotic Stress Tolerance in Crop Plants. Crop J. 2016, 4, 162–176. [Google Scholar] [CrossRef]
- Strobel, G.; Daisy, B.; Castillo, U.; Harper, J. Natural Products from Endophytic Microorganisms. J. Nat. Prod. 2004, 67, 257–268. [Google Scholar] [CrossRef]
- Xu, M.; Huang, Z.; Zhu, W.; Liu, Y.; Bai, X.; Zhang, H. Fusarium-Derived Secondary Metabolites with Antimicrobial Effects. Molecules 2023, 28, 3424. [Google Scholar] [CrossRef]
- Cui, J.-L.; Guo, T.-T.; Ren, Z.-X.; Zhang, N.-S.; Wang, M.-L. Diversity and Antioxidant Activity of Culturable Endophytic Fungi from Alpine Plants of Rhodiola crenulata, R. angusta, and R. sachalinensis. PLoS ONE 2015, 10, e0118204. [Google Scholar] [CrossRef] [PubMed]
- Tejesvi, M.V.; Kajula, M.; Mattila, S.; Pirttilä, A.M. Bioactivity and Genetic Diversity of Endophytic Fungi in Rhododendron tomentosum Harmaja. Fungal Divers. 2011, 47, 97–107. [Google Scholar] [CrossRef]

| Tissue | Segment Studied | Infected Segments | Total Isolates | Endophytic spp. | CR% | IR% | Shanon_H′ |
|---|---|---|---|---|---|---|---|
| Root | 99 | 83 | 86 | 11 | 83 | 86.5 | 2.366 |
| Stem | 99 | 95 | 97 | 9 | 96 | 98 | 2.189 |
| Leaf | 99 | 94 | 96 | 10 | 95 | 97 | 2.282 |
| Endophytes | E. coli | S. aureus | B. subtilis | ||||||
|---|---|---|---|---|---|---|---|---|---|
| μL | 100 | 150 | 200 | 100 | 150 | 200 | 100 | 150 | 200 |
| PAL 04 | - | - | - | - | - | - | 18.3 ± 0.5 | 22.2 ± 0.3 | 24.0 ± 0.1 |
| PAL 05 | - | - | - | - | - | - | 22.2 ± 0.3 | 23.1 ± 0.4 | 25.8 ± 0.1 |
| PAL 13 | - | - | - | 6.1 ± 0.2 | 9.0 ± 0.2 | 10.0 ± 0.2 | 9.4 ± 0.1 | 10.2 ± 0.1 | 11.3 ± 0.2 |
| PAL 23 | 22.3 ± 0.5 | 24.5 ± 0.2 | 27.0 ± 0.1 | 20.1 ± 0.1 | 23.3 ± 0.2 | 25.7 ± 0.1 | - | - | - |
| PAR 03 | 12.1 ± 0.3 | 14.2 ± 0.1 | 18.1 ± 0.3 | 20.2 ± 0.2 | 22.0 ± 0.3 | 23.9 ± 0.2 | 18.2 ± 0.3 | 20.1 ± 0.1 | 22.1 ± 0.2 |
| PAR 06 | - | - | - | 16.2 ± 0.2 | 18.1 ± 0.3 | 20.0 ± 0.2 | 16.1 ± 0.2 | 19.3 ± 0.2 | 22.2 ± 0.1 |
| PAR 16 | 12.0 ± 0.3 | 14.0 ± 0.1 | 16.2 ± 0.3 | 20.2 ± 0.1 | 22.2 ± 0.3 | 24.1 ± 0.2 | 13.3 ± 0.3 | 16.1 ± 0.1 | 18.0 ± 0.2 |
| PAS 04 | 16.3 ± 0.1 | 18.2 ± 0.3 | 20.1 ± 0.2 | 14.1 ± 0.3 | 16.1 ± 0.1 | 18.2 ± 0.1 | 17.8 ± 0.1 | 20.1 ± 0.2 | 22.2 ± 0.3 |
| PAS 13 | 18.1 ± 0.3 | 20.2 ± 0.3 | 22.0 ± 0.3 | 16.1 ± 0.3 | 17.2 ± 0.3 | 17.5 ± 0.5 | 16.2 ± 0.3 | 18.2 ± 0.2 | 20.0 ± 0.1 |
| PAS 14 | - | - | - | 24.1 ± 0.3 | 25.9 ± 0.4 | 27.8 ± 0.5 | 2.0 ± 0.1 | 3.9 ± 0.1 | 5.8 ± 0.3 |
| PAS 26 | - | - | - | 23.7 ± 0.5 | 26.0 ± 0.3 | 27.5 ± 0.4 | 14.2 ± 0.3 | 16.1 ± 0.3 | 17.5 ± 0.3 |
| Positive control 1 | 15.0 ± 0.1 | 16.00 ± 0.2 | 16.9 ± 0.2 | 16.0 ± 00 | 16.3 ± 0.2 | 16.9 ± 0.2 | 20.0 ± 0.1 | 20.1 ± 0.2 | 20.5 ± 0.2 |
| Positive control 2 | - | - | - | - | - | - | - | - | - |
| Negative control | - | - | - | - | - | - | - | - | - |
| Endophytes | C. albicans | A. fumigatus | ||||
|---|---|---|---|---|---|---|
| μL | 100 | 150 | 200 | 100 | 150 | 200 |
| PAL 04 | - | - | - | - | - | - |
| PAL 05 | - | - | - | 1.0 ± 0.2 | 2.0 ± 0.2 | 4.1 ± 0.2 |
| PAL 13 | - | - | - | - | - | - |
| PAL 23 | - | - | - | - | - | - |
| PAR 03 | - | - | - | - | - | - |
| PAR 06 | 6.1 ± 0.2 | 8.1 ± 0.1 | 9.8 ± 0.3 | - | - | - |
| PAR 16 | - | - | - | - | - | - |
| PAS 04 | - | - | - | - | - | - |
| PAS 13 | - | - | - | - | - | - |
| PAS 14 | - | - | - | - | - | - |
| PAS 26 | - | - | - | - | - | - |
| Positive control | 24.1 ± 0.3 | 24.1 ± 0.3 | 24.6 ± 0.3 | 17.1 ± 0.3 | 17.4 ± 0.1 | 17.8 ± 0.3 |
| Negative control | - | - | - | - | - | - |
| Isolates | E. coli | S. aureus | B. subtilis | C. albicans | A. fumigatous |
|---|---|---|---|---|---|
| PAL04 | - | - | 5.1 ± 0.2 | - | - |
| PAL05 | - | - | 6.0 ± 0.1 | - | - |
| PAL23 | 4.2 ± 0.1 | 2.2 ± 0.2 | - | - | - |
| PAR08 | 8.1 ± 0.2 | 11 ± 0.2 | 8.1 ± 0.1 | - | - |
| PAR14 | 8.2 ± 0.2 | 14.2 ± 0.2 | - | - | - |
| PAR16 | 7.2 ± 0.2 | 13.2 ± 0.1 | - | - | - |
| PAS04 | - | 10.1 ± 0.2 | - | - | - |
| PAS07 | 8 ± 0.2 | 11.3 ± 0.3 | 13.0 ± 0.1 | - | - |
| PAS21 | - | 11.1 ± 0.1 | - | - | - |
| Positive control 1 | 16 ± 0.2 | 16.3 ± 0.2 | 21.1 ± 0.2 | - | - |
| Positive control 2 | - | - | - | 24.1 ± 0.3 | 17.4 ± 0.1 |
| Negative control | - | - | - | - | - |
| Sample | Tissue | ITS Identity | Classification | Accession No. |
|---|---|---|---|---|
| PAL05 | Leaf | 99.62% | Fusarium solani | OR054275.1 |
| PAL23 | Leaf | 92.68% | Fusarium oxysporum | OR055969.1 |
| PAS04 | Stem | 99.62% | Fusarium oxysporum | OR055970.1 |
| PAS13 | Stem | 100% | Fusarium solani | OR055971.1 |
| PAR03 | Root | 99.82% | Fusarium solani | OR055974.1 |
| PAR06 | Root | 100% | Fusarium oxysporum | OR055973.1 |
| PAR13 | Root | 99.64% | Fusarium solani | OR055975.1 |
| PAR16 | Root | 100% | Fusarium oxysporum | OR055976.1 |
Disclaimer/Publisher’s Note: The statements, opinions and data contained in all publications are solely those of the individual author(s) and contributor(s) and not of MDPI and/or the editor(s). MDPI and/or the editor(s) disclaim responsibility for any injury to people or property resulting from any ideas, methods, instructions or products referred to in the content. |
© 2023 by the authors. Licensee MDPI, Basel, Switzerland. This article is an open access article distributed under the terms and conditions of the Creative Commons Attribution (CC BY) license (https://creativecommons.org/licenses/by/4.0/).
Share and Cite
Khadka, G.; Annamalai, T.; Shetty, K.G.; Tse-Dinh, Y.-C.; Jayachandran, K. Isolation and Characterization of Fungal Endophytes from Petiveria alliacea and Their Antimicrobial Activities in South Florida. Microbiol. Res. 2023, 14, 1470-1482. https://doi.org/10.3390/microbiolres14030100
Khadka G, Annamalai T, Shetty KG, Tse-Dinh Y-C, Jayachandran K. Isolation and Characterization of Fungal Endophytes from Petiveria alliacea and Their Antimicrobial Activities in South Florida. Microbiology Research. 2023; 14(3):1470-1482. https://doi.org/10.3390/microbiolres14030100
Chicago/Turabian StyleKhadka, Ganesh, Thirunavukkarasu Annamalai, Kateel G. Shetty, Yuk-Ching Tse-Dinh, and Krish Jayachandran. 2023. "Isolation and Characterization of Fungal Endophytes from Petiveria alliacea and Their Antimicrobial Activities in South Florida" Microbiology Research 14, no. 3: 1470-1482. https://doi.org/10.3390/microbiolres14030100
APA StyleKhadka, G., Annamalai, T., Shetty, K. G., Tse-Dinh, Y. -C., & Jayachandran, K. (2023). Isolation and Characterization of Fungal Endophytes from Petiveria alliacea and Their Antimicrobial Activities in South Florida. Microbiology Research, 14(3), 1470-1482. https://doi.org/10.3390/microbiolres14030100







